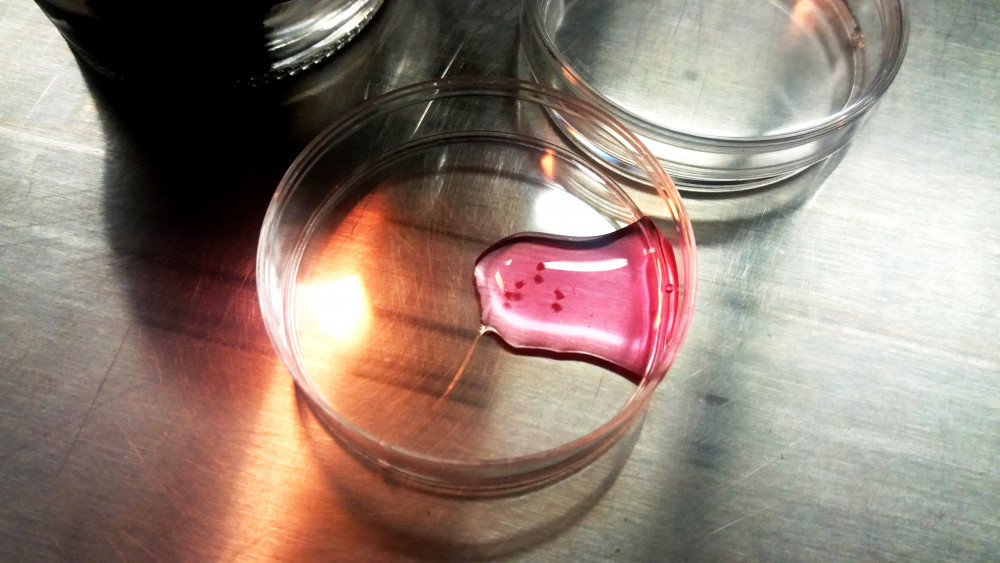

This mixed-media installation aims to present the work behind the previous Trans*Plant project. It combines biomedical research, performance, and speculative fiction. Videos, written narratives, scientific excerpts, mycorrhiza interacting with the audience, and DIY/DIWO biotechnological materials are part of the elements that establish the connection between the theme and the transdisciplinary and experimental form of this lab installation.
Based on self-experimentation, TransPlant is a transdisciplinary project (2016) that utilises living systems. It is a process that involves a human to plant transition in various formats. The project juxtaposes disciplines such as arts, philosophy, biology, ecology, physics, botanics, medicine, nursing, pharmacology, and electronics. TransPlant aims to involve debates surrounding the Anthropocene not based on “human exceptionalness and methodological individualism” (Donna Haraway), but addressing the world and its inhabitants as the product of “cyborg processes”, of “becoming with” (Vinciane Desprets), and of “sympoiesis” (Haraway).
Credits:
With the support of: Hangar.org (ES), Emmetrop (FR), Bandits-Mages (FR), GeniAlis (FR)
The work was realized within the framework of the European Media Art Platforms EMARE program at Ars Electronica Linz GmbH & Co KG with support from the Creative Europe Culture Program of the European Union.
Avec la Participation du DICRéAM – CNC